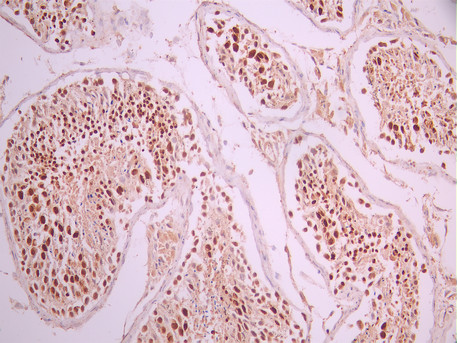

PTBP2 Recombinant Monoclonal Antibody
-
中文名稱:PTBP2 Recombinant Monoclonal Antibody
-
貨號:CSB-RA201933A0HU
-
規格:¥1320
-
圖片:
-
Western Blot
, Positive WB detected in: SH-SY5Y whole cell lysate(30μg), U251 whole cell lysate(30μg), LO2 whole cell lysate(30μg), Mouse brain tissue lysate(30μg), Rat brain tissue lysate(30μg)
All lanes: PTBP2 antibody at 1:1000
Secondary
Goat polyclonal to rabbit IgG at 1/40000 dilution
Predicted band size: 57 kDa
Observed band size: 57 kDa
Exposure time:60s -
IHC image of CSB-RA201933A0HU diluted at 1:100 and staining in paraffin-embedded human testis tissue performed on a Leica BondTM system. After dewaxing and hydration, antigen retrieval was mediated by high pressure in a citrate buffer (pH 6.0). Section was blocked with 10% normal goat serum 30min at RT. Then primary antibody (1% BSA) was incubated at 4°C overnight. The primary is detected by a Goat anti-rabbit polymer IgG labeled by HRP and visualized using 0.05% DAB.
-
IHC image of CSB-RA201933A0HU diluted at 1:100 and staining in paraffin-embedded human liver cancer performed on a Leica BondTM system. After dewaxing and hydration, antigen retrieval was mediated by high pressure in a citrate buffer (pH 6.0). Section was blocked with 10% normal goat serum 30min at RT. Then primary antibody (1% BSA) was incubated at 4°C overnight. The primary is detected by a Goat anti-rabbit polymer IgG labeled by HRP and visualized using 0.05% DAB.
-
Immunofluorescence staining of SH-SY5Y cell with CSB-RA201933A0HU at 1:50 , counter-stained with DAPI. The cells were fixed in 4% formaldehyde, permeabilized using 0.2% Triton X-100 and blocked in 10% normal Goat Serum. The cells were then incubated with the antibody overnight at 4°C. The secondary antibody was Alexa Fluor 488-congugated AffiniPure Goat Anti-Rabbit IgG(H+L).
-
Overlay Peak curve showing SH-SY5Y cells stained with CSB-RA201933A0HU (red line) at 1:100. The cells were fixed in 4% formaldehyde and permeated by 0.2% TritonX-100 for 10min. Then 10% normal goat serum to block non-specific protein-protein interactions followed by the antibody (1ug/1*106cells) for 45min at 4℃. The secondary antibody used was FITC-conjugated goat anti-rabbit IgG (H+L) at 1/200 dilution for 35min at 4℃.Control antibody (green line) was Rabbit IgG (1ug/1*106cells) used under the same conditions. Acquisition of >10, 000 events was performed.
-
-
其他:
產品詳情
-
Uniprot No.:
-
基因名:
-
別名:brPTB antibody; FLJ34897 antibody; MIBP antibody; Neural polypyrimidine tract binding protein antibody; Neural polypyrimidine tract-binding protein antibody; Neurally enriched homolog of PTB antibody; Neurally-enriched homolog of PTB antibody; nPTB 5 antibody; nPTB 6 antibody; nPTB 7 antibody; nPTB 8 antibody; nPTB antibody; nPTB5 antibody; nPTB6 antibody; nPTB7 antibody; nPTB8 antibody; Polypyrimidine tract binding protein 2 antibody; Polypyrimidine tract-binding protein 2 antibody; PTB antibody; PTB like antibody; PTB like protein antibody; PTB-like protein antibody; PTBLP antibody; PTBP 2 antibody; Ptbp2 antibody; PTBP2_HUMAN antibody; Splicing regulator antibody
-
反應種屬:Human, Mouse, Rat
-
免疫原:A synthesized peptide from human PTBP2 protein
-
免疫原種屬:Homo sapiens (Human)
-
標記方式:Non-conjugated
-
克隆類型:Monoclonal
-
抗體亞型:Rabbit IgG
-
純化方式:Affinity-chromatography
-
克隆號:3E1
-
濃度:It differs from different batches. Please contact us to confirm it.
-
保存緩沖液:Rabbit IgG in 10mM phosphate buffered saline , pH 7.4, 150mM sodium chloride, 0.05% BSA, 0.02% sodium azide and 50% glycerol.
-
產品提供形式:Liquid
-
應用范圍:ELISA, WB, IHC, IF, FC
-
推薦稀釋比:
Application Recommended Dilution WB 1:500-1:5000 IHC 1:50-1:200 IF 1:50-1:200 FC 1:50-1:200 -
Protocols:
-
儲存條件:Upon receipt, store at -20°C or -80°C. Avoid repeated freeze.
-
貨期:Basically, we can dispatch the products out in 1-3 working days after receiving your orders. Delivery time maybe differs from different purchasing way or location, please kindly consult your local distributors for specific delivery time.
-
用途:For Research Use Only. Not for use in diagnostic or therapeutic procedures.
相關產品
靶點詳情
-
功能:RNA-binding protein which binds to intronic polypyrimidine tracts and mediates negative regulation of exons splicing. May antagonize in a tissue-specific manner the ability of NOVA1 to activate exon selection. In addition to its function in pre-mRNA splicing, plays also a role in the regulation of translation.; Reduced affinity for RNA.
-
基因功能參考文獻:
- It has been established that PTBP1 and PTBP2 are members of a family of cryptic exon repressors. PMID: 27681424
- PTBP1 and PTBP2 impaired autoregulation of SRSF3 in oral squamous cell carcinoma cancer cells. PMID: 26416554
- Data show that polypyrimidine tract-binding proteins nPTB and ROD1 interact with mitochondrial tRNA(Thr) in the cytoplasm outside of mitochondria. PMID: 26657638
- In T98G glioma cells, the level of sumoylated PTBP2 was reduced compared to that of normal brain cells. Overall, this study shows that PTBP2 is posttranslationally modified by SUMO1. PMID: 24286314
- MALAT1 binds to SFPQ releasing PTBP2 from the SFPQ/PTBP2 complex, the increased SFPQ-detached PTBP2 promotes cell proliferation and migration in colorectal cancer. PMID: 25025966
- Defining the multifunctional roles of PTB will contribute to the understanding of key regulatory events in gene expression. PMID: 24264039
- Changes in miR-223/PTBP2 pathway could contribute of abnormal splicing in chronic myeloid leukemia. PMID: 23174904
- Regulation of the mutually exclusive exons 8a and 8 in the CaV1.2 calcium channel transcript by polypyrimidine tract-binding protein. PMID: 21282112
- present fluorescence, NMR, and in vivo splicing data in support of a role of PTB in inducing RNA loops. We show that the RNA recognition motifs (RRMs) 3 and 4 of PTB can bind two distant pyrimidine tracts and bring their 5' and 3' ends in close proximity PMID: 20160105
- The nPTB proximal promoter, although rich in G+C content and presenting putative binding sites for the transcription factors Sp1, NF-1, NF-kB and Oct-1, lacks a typical TATA box. PMID: 16002244
- Study shows that PTB can function as an anti-repressor molecule to counteract the splicing inhibitory activity of SRp30c. PMID: 17548433
顯示更多
收起更多
-
亞細胞定位:Nucleus.
-
組織特異性:Mainly expressed in brain although also detected in other tissues like heart and skeletal muscle. Isoform 1 and isoform 2 are specifically expressed in neuronal tissues. Isoform 3 and isoform 4 are expressed in non-neuronal tissues. Isoform 5 and isoform
-
數據庫鏈接:
Most popular with customers
-
YWHAB Recombinant Monoclonal Antibody
Applications: ELISA, WB, IHC, IF, FC
Species Reactivity: Human, Mouse, Rat
-
Phospho-YAP1 (S127) Recombinant Monoclonal Antibody
Applications: ELISA, WB, IHC
Species Reactivity: Human
-
-
-
-
-
-